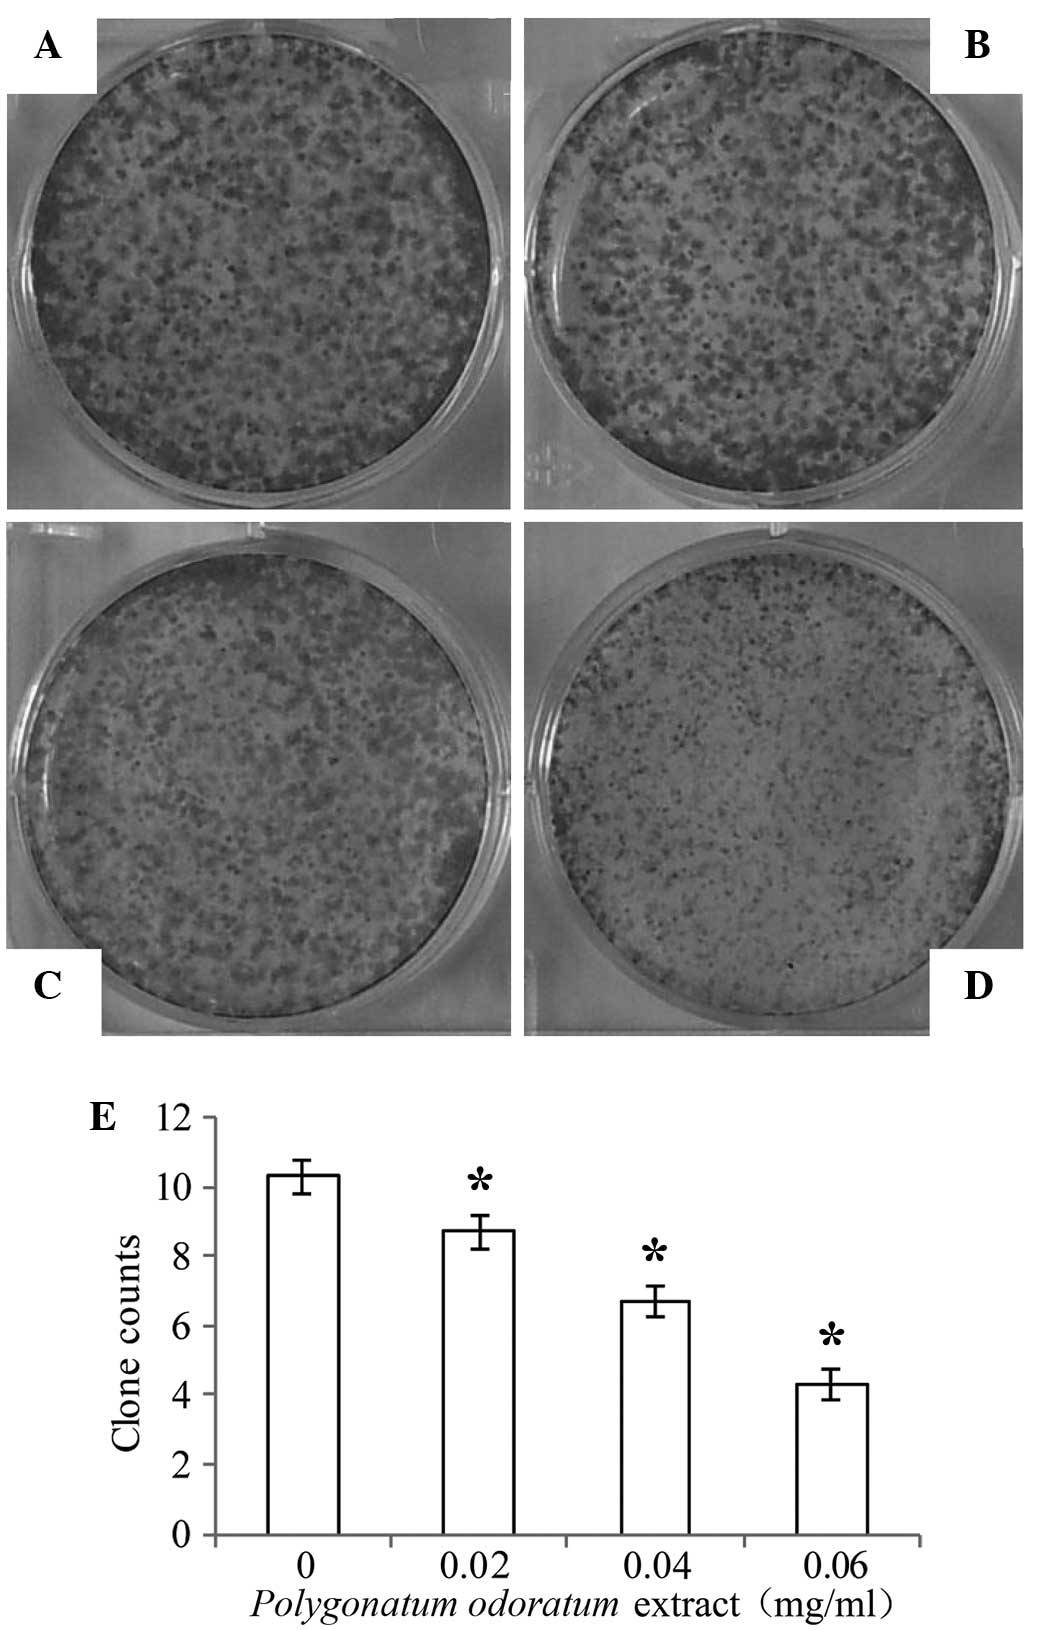

Introduction
Breast cancer is one of the most common malignant
tumors in females, and poses a serious threat to the physical and
mental health of women (1). Breast
cancer patients may be affected by physical and psychological
problems throughout the whole process of disease diagnosis,
treatment and rehabilitation (2,3).
Psychological problems may increase the side effects of treatment
and affect the patient's quality of life (4). Patients with anxiety, depression,
happiness and social support situation will affect the patient's
emotional state (5). In women,
breast cancer is the most common tumor type by incidence and the
second cause of cancer-associated mortality (6,7). Adult
height has been demonstrated to be positively correlated with
breast cancer risk in various epidemiological studies.(8–11).
Statistical data revealed that, among all the malignant tumors
reported, breast cancer has the highest incidence in major cities
in China, as compared with the rest of China (12–15). In
comprehensive breast cancer treatment, based on the present
risk-benefit ratio optimization scheme, surgery is first line of
comprehensive treatment, in addition to chemotherapy, endocrine
therapy, radiation therapy, immune therapy, as well as the use of
traditional Chinese medicine (TCM) therapy (16–20).
Since the majority of tumors develop resistance to certain drugs,
the search for novel antitumor agent is essential. Furthermore,
adequately sensitive apoptosis cannot be induced by
chemotherapy.
TCM occupies an important position in the
development of antitumor drugs. Recent studies have demonstrated
that TCM agents are able to control the growth of tumors, enhance
the body's immune function and improve the therapeutic effect of
chemotherapy drugs (21–23). Polygonatum odoratum (P.
odoratum) is a member of the Liliaceae family and is commonly
used in TCM (24–26). Previous studies have demonstrated
that it increases the level of antibody production, and exerts
anti-inflammatory, antiviral and tumor inhibitory effects (27,28).
P. odoratum has been used to treat various diseases due to
its procoagulant activity (29),
anti-hyperglycemic effect (30,31),
glucose tolerance improvement (32)
and anti-herpes simplex virus-II and apoptosis-inducing activities
(33). P. odoratum has been
suggested as a potential therapeutic target for the treatment of
breast cancer (34,35).
The aim of the present study was to investigate the
effects of P. odoratum extract on breast cancer cells. The
results of the study may provide novel insights that could assist
in the research and development of novel antitumor drugs for the
treatment of breast cancer.
Materials and methods
Cell lines
The MDA-MB-231 breast cancer line (American Type
Culture Collection, Manassas, VA, USA) was cultured in the
laboratory of the Department of Pharmacy, Bengbu Medical College
(Bengbu, China). The cells were cultured in Dulbecco's modified
Eagle's medium (DMEM) supplemented with 10% fetal bovine serum
(FBS), 100 U/ml penicillin and 100 µg/ml streptomycin, and were
maintained at 37°C with 5% CO2 in a humidified
atmosphere. All the experiments were performed on logarithmically
growing cells.
Reagents and antibodies
DMEM, FBS and phosphate-buffered saline (PBS) were
purchased from Thermo Fisher Scientific, Inc. (Grand Island, NY,
USA). MTT [also known as
3-(4,5-dimethylthiazol-2-yl)-2,5-diphenyltetrazolium bromide] was
obtained from Sigma-Aldrich (Castle Hill, Australia). Penicillin
and streptomycin were purchased from North China Pharmaceutical
Group Corp., (Shijiazhuang, China). Propidium iodide (PI)/Annexin
V-FITC was purchased from Sigma-Aldrich (St. Louis, MO, USA).
Dimethyl sulfoxide (DMSO) was obtained from Amresco (Solon, OH,
USA). Mouse anti-human β-actin (1:10,000; 66009-1-Ig) polyclonal
antibody and rabbit anti-B-cell lymphoma-2 (Bcl-2; 1:1,000;
12789-1-AP) and rabbit anti-Bcl-2-associated X protein (Bax;
1:1,000; 23931-1-AP) polyclonal rabbit anti-human antibodies were
purchased from Proteintech Group, Inc. (Rosemont, IL, USA). The
mitochondrial membrane potential (ΔΨm) assay kit (C2006), JC-1,
bicinchoninic acid protein concentration kit (P0011) and crystal
violet stain were purchased from the Beyotime Institute of
Biotechnology (Shanghai, China).
Cell proliferation assay
The effect of the P. odoratum extract on cell
viability was determined using an MTT assay. P. odoratum
extract was socked in MeOH for 3 days isolate the filtrate, MeOH
extract was obtained using rotary evaporators. MeOH extract was
dissolved in a isopyknic mixture of EtOAc and H2O to
obtained the EtOAc layer and the EtOAc extract was isolated using
rotary evaporators. Subsequently, EtOAc extract was dissolved in a
isopyknic mixture of Hexane and H2O to obtain the Hexane
layer, and P. odoratum extract was subsequently obtained
using rotary evaporators. Briefly, the MDA-MB-231 cells were seeded
at a density of 1×104 cells/well in 96-well plates with
100 ml growth medium. The cells were randomly divided into three
groups as follows: Control (no treatment), P. odoratum
extract (treatment with extract alone) and blank control (no cells,
no treatment, just growth medium) groups. Cells in the P.
odoratum extract group were then incubated for 24 h in the
presence of 0, 0.001, 0.01 or 0.1 mg/ml P. odoratum extract.
Next, 15 µl MTT (5 mg/ml) was added to the cells, which were
incubated in the dark at 37°C for 4 h. Subsequent to removal of the
MTT solution, the formazan product (crystals) was dissolved in 150
µl DMSO by shaking the plates for 10 min. Optical density (OD) was
then determined at 490 nm using a Synergy HT multi-detection
microplate reader (BioTek Instruments, Inc., Winooski, VT, USA).
The experiments were performed in triplicate, and three parallel
samples were measured each time. For calculation of the cell
proliferation rate (%), the following formula was used: OD
(experimental group) / OD (control group) × 100.
Colony formation assay
MDA-MB-231 cells in the logarithmic growth period,
were seeded at a density of 1×104 cells/well in 6-well
plates with 2 ml growth medium and incubated for 24 h. Next, the
cells were treated with different concentrations of the P.
odoratum extract (0, 0.02, 0.04 and 0.06 mg/ml) for 5 days and
maintained at 37°C in 5% CO2 in a humidified atmosphere.
The cells were then washed twice with pre-chilled PBS, fixed with
paraformaldehyde for 10 min and stained with 2% crystal violet for
10 min. Double-distilled water was used to clean the cells until
the color of the sample turned transparent, and the cells were then
dried at room temperature. Colonies contained 50–150 cells. Colony
numbers were counted under a light microscope at a magnification of
×40.
Cell apoptosis assay
A single cell suspension was prepared from
MDA-MB-231 cells in the logarithmic growth period and counted using
flow cytometry (Accuri C6; BD Biosciences, Franklin Lakes, NJ,
USA). Annexin-V FITC/PI staining was performed according to the
manufacturer's instructions to assess cellular apoptosis. Cells
were seeded in 6-well culture plates (1×104 cells/well)
for 24 h prior to the cell apoptosis assay. Next, the cells were
incubated with the P. odoratum extract at increasing
concentrations (0, 0.02, 0.04 and 0.06 mg/ml) for 24 h and then
washed twice with pre-chilled PBS. The cells were resuspended in
500 µl binding buffer, following centrifugation at 13,223 × g for
10 min. Subsequently, 100 µl cell suspension was transferred to
5-ml Eppendorf tubes, and 5 µl PI/Annexin V-FITC solution was added
to each tube and mixed for 15 min (4°C; dark). Following incubation
for 15 min at 20°C, the apoptosis rate was determined using an BD
Accuri C6 flow cytometer, and the results were analyzed using the
flow cytometer software.
Western blot analysis
Stable expression cells were washed three times with
cold PBS (1 ml/well) and digested with trypsin in lysis buffer for
30 min on ice. The protein concentrations of the cell lysates were
detected using a bicinchoninic acid protein concentration kit. The
protein sample was mixed with the sample buffer (2:1) and boiled at
100°C with the denaturation buffer for 5 min, and steps were taken
to prevent protein degradation. Protein samples from each test
group (30 µg) were subjected to 10% sodium dodecyl
sulfate-polyacrylamide gel electrophoresis. A condensation protein
electrophoresis gel was run at 70 V for 30 min and 150 V for 90
min, and the proteins were transferred onto polyvinylidene fluoride
membranes at 50 V in an ice bath for 90 min. The membrane was then
blocked in 5% skim milk, followed by an overnight incubation at 4°C
with the primary antibodies against β-actin. Bcl-2 and Bax
(1:1000). Subsequently, the membrane was washed three times with
Tris PBS (TPBS) and once with PBS, for 10 min each time. The sample
was then labeled with the peroxidase-conjugated rabbit (109525) or
mouse (117228) secondary antibodies (1:5,000; ZSGB Bio, Beijing,
China) for 2 h at room temperature on a shaker. Next, the membrane
was washed with TPBS, and the bands were visualized using western
lightning with enhanced chemiluminescence (EMD Millipore,
Billerica, MA, USA). β-actin was used as the protein control, and
the gray values of the protein bands in each group were analyzed
using Quantity One 4.6.8.27 gel image analysis software (Bio-Rad
Laboratories, Inc., Hercules, CA, USA). The experiments were
repeated at least twice to confirm the results.
Measurement of ΔΨm
The mitochondrial stability was assessed using a ΔΨm
assay kit with JC-1. MDA-MB-231 cells in the logarithmic growth
period were seeded at a density of 2×105 cells/well in
12-well plates with 1 ml growth medium and incubated for 24 h.
Next, the cells were treated with 0.1 mg/ml of the drug. After
treatment for 24 h, the cells were washed once with PBS and then
incubated with 1 ml JC-1 fluorescent dye for 20 min in the dark at
37°C. Subsequently, the cells were washed twice with pre-chilled
buffer solution. The ΔΨm was imaged using a fluorescence microscope
(Olympus Corp., Tokyo, Japan) at 550 nm excitation and 570 nm
emission.
Statistical analysis
All experiments were performed at least in
triplicate. Data are presented as the mean ± standard error of the
mean. A double-sided Dunnett's test was used for between-group
comparisons. All statistical analyses were performed using the SPSS
version 13.0 software (SPSS, Inc., Chicago, IL, USA) and
statistically significant differences were indicated by
P<0.05.
Results
Inhibitory effects of P. odoratum
extract on the viability and proliferation of MDA-MB-231 cells
An MTT assay was performed to determine the effect
of P. odoratum extract on the proliferation of MDA-MB-231
cells. As shown in Fig. 1, the
viability of MDA-MB-231 cells was altered following 24-h treatment
with various concentrations of the P. odoratum extract up to
0.1 mg/ml. The extract inhibited MDA-MB-231 cell proliferation in a
dose-dependent manner (P<0.05).
Furthermore, the colony forming ability of the
MDA-MB-231 cells was analyzed using a colony formation assay. As
shown in Fig. 2 (P<0.05), a
significant inhibitory effect was observed in cells treated with
increasing concentrations of the P. odoratum extract (0,
0.02, 0.04 and 0.06 mg/ml) for 5 days, while low concentration
significantly inhibited the cell colony formation. These results
suggest that the P. odoratum extract has inhibitory effects
on breast cancer cell proliferation.
Effect of P. odoratum extract on the
apoptosis of MDA-MB-231 cells
To determine whether the reduced cell viability was
due to apoptosis, PI/Annexin V FITC double staining using the
Accuri C6 flow cytometry was conducted. As indicated in Fig. 3 (P<0.05), MDA-MB-231 cells treated
with increasing concentrations (0.02, 0.04 and 0.06 mg/ml) of the
extract showed an increase in the ratio of apoptotic cells (7.9,
18.1, and 33.2%, respectively) for 24 h. These data showed that the
P. odoratum extract induced dose-dependent apoptosis in the
cells.
Effect of P. odoratum extract on the
protein expression levels of Bcl-2 and Bax
MDA-MB-231 cells were treated with the 0.1 mg/ml
P. odoratum extract for 0, 6, 16, and 24 h, and western blot
analysis was used to investigate the effect on the protein
expression levels of Bcl-2 and Bax. The results showed that,
compared with the control group, there was a time-dependent
decrease and increase in the protein expression levels of Bcl-2 and
Bax, respectively (Fig. 4;
P<0.05). These findings indicate that the extract treatment
resulted in downregulation of Bcl-2 and upregulation of Bax.
β-actin expression was used as an internal control, and its level
was not changed.
Determination of ΔΨm using JC-1
The ΔΨm following JC-1 staining was also examined
using fluorescence analysis. The results indicated that there was a
significant change in the ΔΨm loss in MDA-MB-231 cells following
treatment with the P. odoratum extract (0.1 mg/ml, 24 h). As
shown in Fig. 5, fluorescence
conversion from red to green was observed in response to the
extract treatment. This illustrates the early apoptosis that
occurred in the cells subsequent to treatment. The intensity of the
JC-1 staining was measured using fluorescence microscopy. JC-1
passed across the membrane into the living cells and aggregated in
the mitochondrial membrane, and the concentration of JC-1 increased
as mitochondrial membrane potential increased. When the ΔΨm is
high, JC-1 accumulates in the mitochondrial matrix forming J
aggregates and red fluorescence is produced. By contrast, when the
ΔΨm is low, JC-1 cannot accumulate in the mitochondrial matrix and
the monomer with the green fluorescence is produced. Therefore, the
ΔΨm can be easily determined based on the fluorescent color change,
and a decrease in ΔΨm is a sign of early apoptosis. Change in
fluorescence from red to green induced by JC-1 can easily be
detected with the decline of the membrane potential. Therefore,
JC-1 staining can be used as an index for the detection of early
apoptosis.
Discussion
Recent research has been focusing on the search for
novel antitumor drugs (36). The
present study demonstrated that the P. odoratum extract
inhibited the proliferation of the breast cancer MDA-MB-231 cell
line, enhanced the expression of Bax, inhibited Bcl-2 and reduced
the ΔΨm, thereby resulting in MDA-MB-231 cell apoptosis.
Under physiological and pathological stimuli, normal
cells undergo a spontaneous death process known as apoptosis. This
process is active, highly ordered, signal-dependent, and controlled
by genes and a series of enzymes. The initiation of the apoptotic
process directly determines the ‘fate’ of the cell (37,38). A
high expression of the Bcl-2 gene maintains cell survival and has
no effect on cell proliferation, as first demonstrated by Vaux
et al in 1988 (39). The main
physiological function of the Bcl-2 protein is inhibition of
apoptosis, thereby prolonging the life of cells without any effect
on cell differentiation (40).
Furthermore, the expression of other genes of the Bcl-2 family
serves an important role in the process of apoptosis, which
includes mitochondrial regulation (41,42).
Numerous apoptotic cells exhibit enhanced expression of Bax, which
is the most widely studied pro-apoptotic protein in the Bcl-2
family (43). Alsabeh et al
(44) examined the expression of
Bcl-2 in 371 cases of breast cancer, and identified a positive
expression as high as 79.3%, while a generally strong intensity of
staining was observed, indicating that the Bcl-2 test for the
clinical diagnosis of breast cancer has a reference value. In the
present study, expression levels of Bcl-2 increased and Bax
decreased, as compared with the original tissues. Bax/Bcl-2
downregulation exhibited significance. The present findings that
the expression levels of Bax and Bcl-2 increased and decreased,
respectively, may indicate that a mechanism that promotes various
factors that induce tumor cell apoptosis.
JC-1 is an ideal fluorescent probe and is widely
used in the detection of ΔΨm in purified cells or tissues (45). When the ΔΨm is high, JC-1 accumulates
in the mitochondrial matrix forming J-aggregates and red
fluorescence is produced (46). By
contrast, when the ΔΨm is low, JC-1 cannot accumulate in the
mitochondrial matrix and the monomer with the green fluorescence is
produced (47–49). Therefore, the ΔΨm can be easily
determined based on the fluorescent color change, and a decrease in
ΔΨm is a sign of early apoptosis (50). Change in fluorescence from red to
green induced by JC-1 can easily be detected with the decline of
the membrane potential. Thus, JC-1 staining can be used as an index
for the detection of early apoptosis. In the present study, red
fluorescence intensity was attenuated, whereas the intensity of
green fluorescence enhanced. These findings indicated that the
mitochondrial membrane potential declined and apoptosis was
activated.
In conclusion, the present study revealed that the
P. odoratum extract inhibited the proliferation and induces
the apoptosis of human breast cancer MDA-MB-231 cells. This
treatment was also found to affect the expression of
apoptosis-associated proteins. These results suggest that the P.
odoratum extract may have certain value in the treatment of
breast cancer. However, the molecular mechanism involved in the
extracts' effects requires further elucidation. Furthermore,
toxicological and in vivo experiments are also necessary to
confirm the findings of the present study.
Acknowledgements
The present study was supported by grants from the
National Natural Science Foundation of China (nos. 81000992 and
81372899), the Natural Science Foundation of Anhui Province (no.
1508085MH166) and the National Training Programs of Innovation and
Entrepreneurship for Undergraduates (no. 201310367037).
References
|
1
|
Ferlay J, Shin HR, Bray F, Forman D,
Mathers C and Parkin DM: Estimates of worldwide burden of cancer in
2008: GLOBOCAN 2008. Int J Cancer. 127:2893–2917. 2010. View Article : Google Scholar : PubMed/NCBI
|
|
2
|
Kim SH, Son BH, Hwang SY, Han W, Yang JH,
Lee S and Yun YH: Fatigue and depression in disease-free breast
cancer survivors: prevalence, correlates, and association with
quality of life. J Pain Symptom Manage. 35:644–655. 2008.
View Article : Google Scholar : PubMed/NCBI
|
|
3
|
Fann JR, Thomas-Rich AM, Katon WJ, Cowley
D, Pepping M, McGregor BA and Gralow J: Major depression after
breast cancer: A review of epidemiology and treatment. Gen Hosp
Paychiatry. 30:122–126. 2008.
|
|
4
|
Karakoyun-Celik O, Gorken I, Sahin S,
Orcin E, Alanyali H and Kinay M: Depression and anxiety levels in
woman under follow-up for breast cancer: Relationship to coping
with cancer and quality of life. Med Oncol. 27:108–113. 2010.
View Article : Google Scholar : PubMed/NCBI
|
|
5
|
Xu LX, Shen SS, He JJ, Fu Y, Xue XD, Liang
Y, Lin Y, Zhang XH and He JC: Relationship among anxiety,
depression, well-being index and social support in breast cancer
patients. Zhong Guo Xin Li Wei Sheng Za Zhi. 27:473–478. 2013.
|
|
6
|
DeSantis C, Ma J, Bryan L and Jemal A:
Breast cancer statistics, 2013. CA Cancer J Clin. 64:52–62. 2014.
View Article : Google Scholar : PubMed/NCBI
|
|
7
|
Ferlay J, Soerjomataram I, Dikshit R, Eser
S, Mather C, Rebelo M, Parkin DM, Forman D and Bray F: Cancer
incidence and mortality worldwide: sources, methods and major
patterns in GLOBOCAN 2012. Int J Cancer. 136:E359–E386. 2015.
View Article : Google Scholar : PubMed/NCBI
|
|
8
|
Green J, Cairns BJ, Casabonne D, Wright
FL, Reeves G and Beral V: Million Women Study collaborators: Height
and cancer incidence in the Million Women Study: prospective
cohort, and meta-analysis of prospective studies of height and
total cancer risk. Lancet Oncol. 12:785–794. 2011. View Article : Google Scholar : PubMed/NCBI
|
|
9
|
Mellemkjaer L, Christensen J, Frederiksen
K, Baker JL, Olsen A, Sørensen TI and Tjønneland A: Leg length,
sitting height and postmenopausal breast cancer risk. Br J Cancer.
107:165–168. 2012. View Article : Google Scholar : PubMed/NCBI
|
|
10
|
Ritte R, Lukanova A, Tjonneland A, Olsen
A, Overvad K, Mesrine S, Fagherazzi G, Dossus L, Teucher B,
Steindorf K, et al: Height, age at menarche and risk of hormone
receptor-positive and -negative breast cancer: A cohort study. Int
J Cancer. 132:2619–2629. 2013. View Article : Google Scholar : PubMed/NCBI
|
|
11
|
Kabat GC, Kim MY, Hollenbeck AR and Rohan
TE: Attained height, sex, and risk of cancer at different anatomic
sites in the NIH-AARP Diet and Health Study. Cancer Causes Control.
25:1697–1706. 2014. View Article : Google Scholar : PubMed/NCBI
|
|
12
|
Ni ZJ, Wang HS and Chen YX: The trend
analysis of mortality with female breast cancer during 1989-2008,
Haimen city. Jiang Su Yu Fang Yi Xue. 20:1–3. 2009.(In
Chinese).
|
|
13
|
Pan XD, Wang HW and Li X: Breast cancer
mortality tendency among women from 1992 to 2006 in Shenyang. Zhong
Guo Fu You Bao Jian. 23:4703–4705. 2008.(In Chinese).
|
|
14
|
Wang Y, Ma Q, Li HQ, Diao YT, Yin C, Ciu
YC, Xu AQ, Ma JQ and Guo XL: Changing trend of female breast cancer
mortality in Shandong province, 1970-2005. Zhong Hua Zhong Liu Fang
Zhi Za Zhi She. 16:729–732. 2009.(In Chinese).
|
|
15
|
Liang YQ: Analysis of female breast cancer
mortality in Nanjing in 1997-2005. Zhi Ye Yu Jian Kang. 23:357–358.
2007.(In Chinese).
|
|
16
|
Blichert-Toft M, Nielsen M, During M,
Møller S, Rank F, Overgaard M and Mouridsen HT: Long-term results
of breast conserving surgery vs. mastectomy for early stage
invasive breast cancer: 20-year follow-up of the Danish randomized
DBCG-82TM protocol. Acta Oncol. 47:672–681. 2008.
|
|
17
|
Goldhirsch A, Wood WC, Gelber RD, Coates
AS, Thürlimann B and Senn HJ: 10th St. Gallen conference: Progress
and promise: Highlights of the international expert consensus on
the primary therapy of early breast cancer 2007. In: Ann Oncol. 18.
pp. 1133–1144. 2007; View Article : Google Scholar : PubMed/NCBI
|
|
18
|
Ahunbay EE, Robbins J, Christian R, Godley
A, White J and Li XA: Interfractional target variations for partial
breast irradiation. Int J Radiat Oncol Biol Phys. 82:1594–1604.
2012. View Article : Google Scholar : PubMed/NCBI
|
|
19
|
Yamashiro H and Toi M: Molecular targeted
therapy for breast cancer treatment, challenge to cure. Nihon
Rinsho. 68:1854–1858. 2010.(In Japanese). PubMed/NCBI
|
|
20
|
Chen SS and Yu ZH: Recent research on
traditional Chinese medicine in the treatment of breast cancer.
Modern Oncology. 23:2072–2077. 2015.
|
|
21
|
Kim J, Han JY, Shaw B, McTavish F and
Gustafson D: The roles of social support and coping strategies in
predicting breast cancer patients' emotional well-being: Testing
mediation and moderation models. J Health Psychol. 15:543–552.
2010. View Article : Google Scholar : PubMed/NCBI
|
|
22
|
Li J, Huang XY, Zou XZ, Wei W and Wang ZX:
Clinical curative effect of traditional Chinese medicine, western
medicine Fuzheng attack comprehensive treatment of malignant tumor.
Zhong Guo Yi Yao Dao Kan. 3:529–530. 2014.(In Chinese).
|
|
23
|
Chen YE, Wang SP, Hu YY, Chen MW and Wang
YT: Research in novel drug delivery system of anti-tumor Chinese
medicine (part three) - Fuzheng guben Chinese medicine. Shi Jie Ke
Xue Ji Shu-Zhong Yi Yao Xian Dai Hua. 2:201–206. 2013.(In
Chinese).
|
|
24
|
Commission of Pharmacopoeia, . Chinese
Pharmacopoeia: Part One. China Medical Science and Technology
Press; Beijing: 2010
|
|
25
|
He Zhijun: A summary on 42 cases of type 2
diabetes treated by Gegeng Danshen Yuzhu decoction. Hu Nan Zhong Yi
Za Zhi. 24:10–11. 2008.
|
|
26
|
Shu XS, Lv JH, Tao J, Li GM, Li HD and Ma
N: Antihyperglycemice effects of total flavonoids from Polygonatum
odoratum in STZ and alloxan-induced diabetic rats. J
Ethnopharmacol. 124:539–543. 2009. View Article : Google Scholar : PubMed/NCBI
|
|
27
|
Yang HJ, Yang SH, Zhang HT, Ma L and Zhang
LC: Polygonatum odoratum chemical composition, pharmacological
effects research progress and the present situation of the
development and utilization. Ren Shen Yan Jiu. 3:40–45. 2012.(In
Chinese).
|
|
28
|
Li CY, Pan XY, Zhang MC and Liu H: The
antineoplastic mechanism of the extract B of Polygonatum odoratum.
Zhong Guo Mian Yi Xue Za Zhi. 4:253–254. 2003.(In Chinese).
|
|
29
|
Zhang H, Chen L, Kou JP, Zhu DN, Qi J and
Yu BY: Steroidal sapogenins and glycosides from the fibrous roots
of Polygonatum odoratum with inhibitory effect on tissue factor
(TF) procoagulant activity. Steroids. 89:12014. View Article : Google Scholar : PubMed/NCBI
|
|
30
|
Deng Y, He K, Ye X, Chen X, Huang J, Li X,
Yuan L, Jin Y, Jin Q and Li P: Saponin rich fractions from
Polygonatum odoratum (Mill.) Druce with more potential hypoglycemic
effects. J Ethnopharmacol. 141:228–233. 2012. View Article : Google Scholar : PubMed/NCBI
|
|
31
|
Park S, Hong SM, Ahn IS, Kim YJ and Lee
JB: Huang-Lian-Jie-Du-Tang supplemented with Schisandra chinensis
Baill and Polygonatum odoratum Druce improved glucose tolerance by
potentiating insulinotropic actions in islets in 90%
pancreatectomized diabetic rats. Biosci Biotechnol Biochem.
73:2384–2392. 2009. View Article : Google Scholar : PubMed/NCBI
|
|
32
|
Park S, Hong SM, Ahn IS, Kim YJ and Lee
JB: Huang-Lian-Jie-Du-Tang supplemented with Schisandra chinensis
Baill. and Polygonatum odoratum Druce improved glucose tolerance by
potentiating insulinotropic actions in islets in 90%
pancreatectomized diabetic rats. Biosci Biotechnol Biochem.
73:2384–2392. 2009.
|
|
33
|
Yang Y, Xu HL, Zhang ZT, Liu JJ, Li WW,
Ming H and Bao JK: Characterization, molecular cloning, and in
silico analysis of a novel mannose-binding lectin from Polygonatum
odoratum (Mill.) with anti-HSV-II and apoptosis-inducing
activities. Phytomedicine. 18:748–755. 2011. View Article : Google Scholar : PubMed/NCBI
|
|
34
|
Ouyang L, Chen Y, Wang XY, Lu RF, Zhang
SY, Tian M, Xie T, Liu B and He G: Polygonatum odoratum lectin
induces apoptosis and autophagy via targeting EGFR-mediated
Ras-Raf-MEK-ERK pathway in human MCF-7 breast cancer cells.
Phytomedicine. 21:1658–1665. 2014. View Article : Google Scholar : PubMed/NCBI
|
|
35
|
Rafi MM and Vastano BC: Identification of
a structure specific Bcl-2 phosphorylating homoisoflavone molecule
from Vietnamese coriander (Polygonatum odoratume) that induces
apoptosis and G2/M cell cycle arrest in breast cancer cell lines.
Food Chem. 104:332–340. 2007. View Article : Google Scholar
|
|
36
|
Yang H, Huang WR and Yu L: Clinical
application and research process of novel antitumor drug. J New
Med. 19:480–485. 2010.
|
|
37
|
Vaux DL: Apoptosis timeline. Cell Death
Differ. 9:349–354. 2002. View Article : Google Scholar : PubMed/NCBI
|
|
38
|
Edinger AL and Thompson CB: Death by
design: Apoptosis, necrosis and autophagy. Curr Opin Cell Biol.
16:663–669. 2004. View Article : Google Scholar : PubMed/NCBI
|
|
39
|
Vaux DL, Cory S and Adams JM: Bcl-2 gene
promotes haemopoietic cell survival and cooperates with c-myc to
immortalize pre-B cells. Nature. 335:440–442. 1988. View Article : Google Scholar : PubMed/NCBI
|
|
40
|
Wang T, Liu CZ, Liu YZ, Yu JC and Han JX:
Research progress of Bcl-2/Bax gene regulated mechanism for
organism cell apoptosis. Zhong Guo Lao Nian Xue Za Zhi.
16:1658–1660. 2008.(In Chinese).
|
|
41
|
Li M and Lin J: The apoptotic pathways and
their mechanisms. Guo Ji Fu Chan Ke Xue Za Zhi. 2:103–107. 2014.(In
Chinese).
|
|
42
|
Xu RR and Li YD: Research progress of
Bcl-2 families interact with mitochondrial apoptosis pathway. Zhong
Guo Lao Nian Xue Za Zhi. 12:2977–2979. 2013.(In Chinese).
|
|
43
|
Oltvai ZN, Milliman CL and Korsmeyer SJ:
Bcl-2 heterodimerizes in vivo with a conserved homolog, Bax, that
accelerates programmed cell death. Cell. 74:609–619. 1993.
View Article : Google Scholar : PubMed/NCBI
|
|
44
|
Alsabeh R, Wilson CS, Ahn CW, Vasef MA and
Battifora H: Expression of Bcl-2 by breast cancer: A possible
diagnostic application. Mod Pathol. 9:439–444. 1996.PubMed/NCBI
|
|
45
|
Garner DL, Thomas CA, Joerg HW, DeJarnette
JM and Marshall CE: Fluorometric assessments of mitochondrial
function and viability in cryopreserved bovine spermaotozoa. Biol
Reprod. 57:1401–1406. 1997. View Article : Google Scholar : PubMed/NCBI
|
|
46
|
Castedo M, Ferri K, Roumier T, Métivier D,
Zamzami N and Kroemer G: Quantitation of mitochondrial alterations
associated with apoptosis. J Immunol Methods. 265:39–47. 2002.
View Article : Google Scholar : PubMed/NCBI
|
|
47
|
Baxa DM, Luo X and Yoshimura FK: Genistein
induces apoptosis in T lymphoma cells via mitochondrial damage.
Nutr Cancer. 51:93–101. 2005. View Article : Google Scholar : PubMed/NCBI
|
|
48
|
Tan YC, Chen ZJ, Lu SM and Gao X:
Detection of mitochondrial membrane potential changes in
spermatozoa by fluorescent dyes JC-1. Shan Dong Da Xue Xue Bao.
5:447–450. 2006.(In Chinese).
|
|
49
|
Xia XY, Wu YM, Hou BS, Yang B, Pan LJ, Shi
YC, Jin BF, Shao Y, Cui YX and Huang YF: Evaluation of sperm
mitochondrial membrane potential by JC-1 fluorescent staining and
flow cytometry. Zhonghua Nan Ke Xue. 14:135–138. 2008.(In Chinese).
PubMed/NCBI
|
|
50
|
Wang L, Yao SM and Wang Q: The mechanism
of mitochondrial impairment induced by cadmium. Huan Jing Yu Zhi Ye
Yi Xue. 23:73–75. 2006.(In Chinese).
|